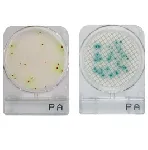

MEDIOS CROMOGÉNICOS COMPACT DRY®
Los medios de cultivo cromogénicos son una clase especial de medios utilizados en microbiología que permiten e identificación de los microorganimos en función de la coloración de las colonias que forman. Esta coloración proviene de sustancias contenidas en los medios y que interfieren con rutas metabólicas específicas del microorganismo/s que se desea identificar.
CompactDry® es un método listo para usar para minimizar el tiempo de análisis microbiano y mejorar los procesos de control de calidad. CompactDry® son medios deshidratados, selectivos y cromogénicos para recuento total y/o identificación de especies microbianas. Se puede aplicar para controlar materias primas y productos alimentarios, bebidas, cosméticos y en controles ambientales de aire y/o superficies.


 Resto del Mundo
Resto del Mundo